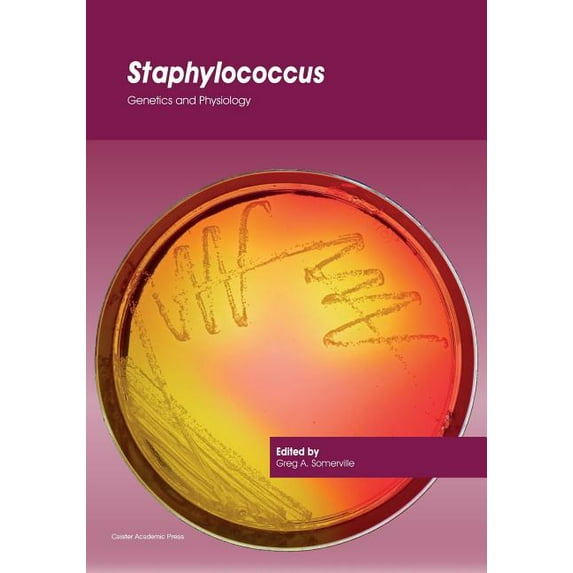
Staphylococcus: Genetics and Physiology (Paperback)

Current price is USD$219.21
Price when purchased online
- Free shipping
- Free 30-day returns
How do you want your item?
Columbus, 43215
Arrives between Apr 10 - Apr 13
|Sold and shipped by Alibris Books
4.5644061375260465 stars out of 5, based on 10558 seller reviews(4.6)
Free 30-day returns
More seller options (2)
Starting from $238.25
About this item
Customer ratings & reviews
0 ratings|0 reviews
This item does not have any reviews yet




















